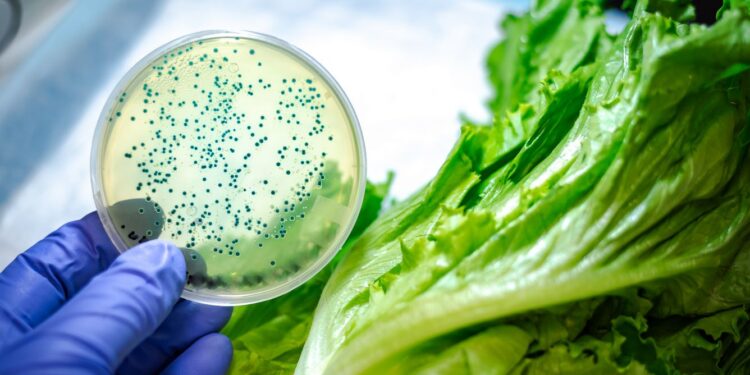

I ricercatori della Pudrue University hanno sviluppato un trattamento per le superfici metalliche a base di peptidi antimicrobici che abbatte la popolazione batterica
L’attenzione verso la pulizia e la sanificazione oggi è un argomento più caldo che mai. La pulizia degli ambienti dove si produce il cibo è fondamentale per evitare il proliferare di malattie batteriche indesiderate. I ricercatori della Purdue University hanno recentemente annunciato la loro nuova invenzione. Il team è riuscito a produrre un rivestimento a base di peptidi con funzione antimicrobica, in grado quindi di uccidere i batteri al contatto. Il rivestimento è costituito da soli peptidi, risulta quindi completamente atossico e biocompatibile.
Potrebbe interessarti anche -> New-Gen Faucet, il nuovo dispenser touchless
Il materiale è applicato sulle superfici metalliche e si inserisce nelle sue microcrepe. I peptidi vengono quindi rilasciati nel tempo, aumentando il tempo di efficienza del rivestimento. Il processo antimicrobico genera l’ossidazione dei peptidi, visibile facilmente grazie al cambio di colore della superficie. La variazione di colore avverte chiaramente quando la superficie ha bisogno di un nuovo trattamento. Per il momento è stata dimostrata l’efficienza del rivestimento su superfici di metallo inossidabile e titanio ma è applicabile anche ad altri metalli.
Potrebbe interessarti anche -> I sensori biomedici si disegneranno con le matite?
Il rivestimento può essere applicato sui banconi dove si lavora il cibo e sui coltelli. Un utilizzo molto più interessante coinvolge le superfici dei macchinari di trasporto e di taglio, solitamente difficili da raggiungere. La proprietà antimicrobica delle superfici unita alle fasi di lavaggio del cibo dovrebbe assicurare una sicurezza e pulizia del cibo senza precedenti. “La nostra tecnologia può aiutare ad evitare il trasferimento di batteri da una superficie contaminata ad un utensile da taglio. Questo evita la contaminazione di molti più parti operanti in un impianto di lavorazione alimentare” dice David Bahr, il Professore che ha diretto la ricerca. Il team ora è in cerca di partner per commercializzare la tecnologia.